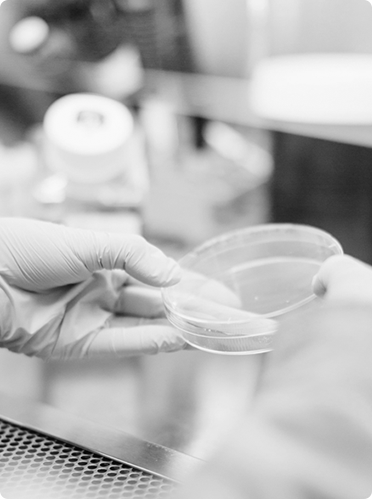

Непрерывное развитие
В 2014г. Kit-Stroy group подписывает меморандум с правительством Айшанской области (провинция Леонин) Китая о продвижении крупных промышленных предприятий данной области в Россию.
Заключаются договора с SBW (полный цикл производства турбомашин, центробежных, аксиальных и поршневых компрессоров, центробежных воздуходувки и насосов. SBW занимает 80% рынка Китая и имеет установки более чем в 40 странах)
Ведутся переговоры со многими крупными инвестиционными промышленными группами